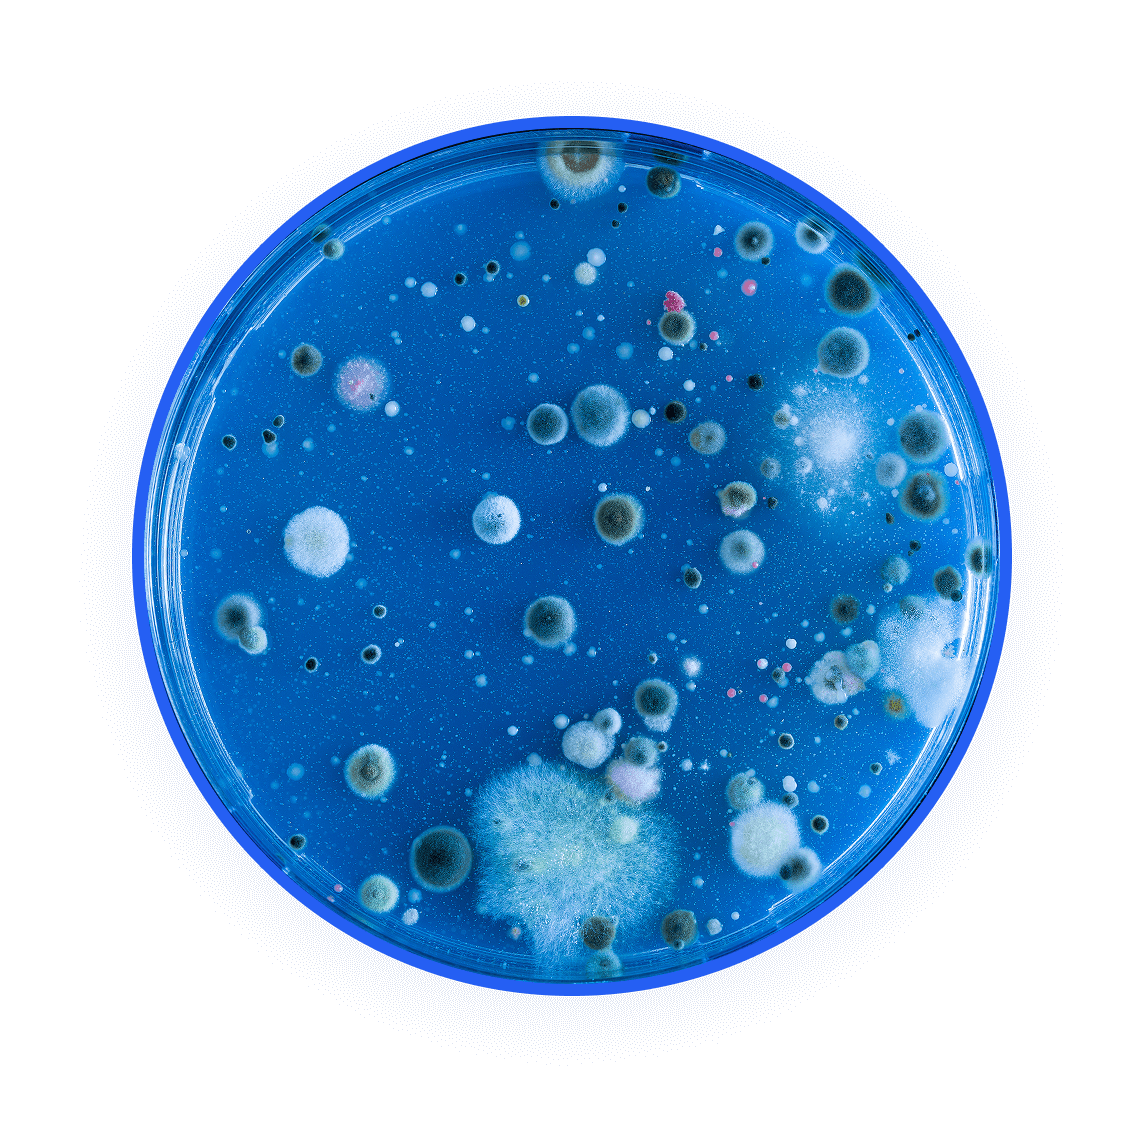

Buy 2 Get 1 FREE
& Fast Shipping From USA










The Swissklip HaloUV is powered by the same technology found in hospitals & airlines to sanitize and sterilize rooms, killing bed bugs & germs by destroying their DNA & RNA.
It’s 99.9% effective, & guaranteed to give you safer and healthier home!




Swissklip HaloUV is a revolutionary UV sterilizer powered by medical grade technology, safe and easy for anyone to use at home and effortlessly eliminate bed bugs, germs, mold, odors, and more.
The UV Sterilizer from Swissklip HaloUV is powered by the same technology found in hospitals and airlines to sanitize and sterilize rooms, killing germs and bacteria by destroying their DNA and RNA.
It’s 99.9% effective, and guaranteed to give you safer, healthier, allergen-free air!






Protecting your family killing germs and removing allergens you can’t even see!
Even if your home doesn’t look dusty and dirty, it could have billions of microscopic germs, bacteria, viruses, and allergens, putting your and your family at risk…
Not to mention dust mites leaving eggs and feces in your bed. The Swissklip HaloUV is the easiest way to eliminate harmful invaders and get long-lasting relief from allergies all year long.

Excellent! The room smells cleaner and the dust is almost nonexistent now. Super happy with this purchase.
















Plug the device in. Make sure there are no pets, plants, or children in the area.


Use the remote control and set the timer by choosing your desired setting. Leave the room and close the door.


Enjoy the fresh scent and peace of mind from eliminating billions of dangerous germs, mold spores, bed bug eggs, irritating allergens, and nasty odors.
Fresh Home, Healthier Family & Protected Surfaces – Or Your Money Back


We’re confident you’ll love the product but if you’re not satisfied with the results, simply inform us within 30 days of purchase for a full refund.
Just contact our amazing customer support team via e-mail at support@swissklip.com and ask for a full refund.










Leveraging medical-grade UV-C light technology, the HaloUV eliminates up to 99.9% of harmful microorganisms, including germs, bacteria, viruses, and allergens, making your living environment safer and healthier.
Yes, by destroying odor-causing bacteria and mold, the HaloUV effectively reduces stubborn smells from pets, cooking, and damp areas, leaving your home fresher
Absolutely. With an intuitive remote control and a simple timer function, the HaloUV is designed for ease of use, ensuring a hassle-free sanitization experience for everyone.
Unlike conventional cleaning that might miss invisible pathogens or rely on chemicals, the HaloUV offers a deep, hands-free clean without harsh chemicals, targeting surfaces and air for a comprehensive sanitization.
Yes, its lightweight and portable design allows you to easily use the HaloUV across various rooms, ensuring thorough sanitization wherever it’s needed.
Sanitization times can vary from 15 to 60 minutes depending on room size. Regular use, especially in high-traffic areas or during allergy seasons, is recommended to maintain a clean and healthy environment.
We offer a 100% money-back guarantee. If you’re not fully satisfied within 30 days of purchase, contact our customer support for a full refund, providing a risk-free way to experience the benefits of the HaloUV.


Notice: This product is classified as a pesticidal device under EPA regulations and is intended for the sanitization of non-porous surfaces and air. It is not an FDA-cleared medical device and is not intended to diagnose, treat, or prevent any disease. This device should be used strictly as a supplement to, and not a replacement for, standard cleaning and disinfection protocols. Please take a moment to read the included safety warnings and operating instructions in full before your first use to ensure you get the best (and safest) results.

